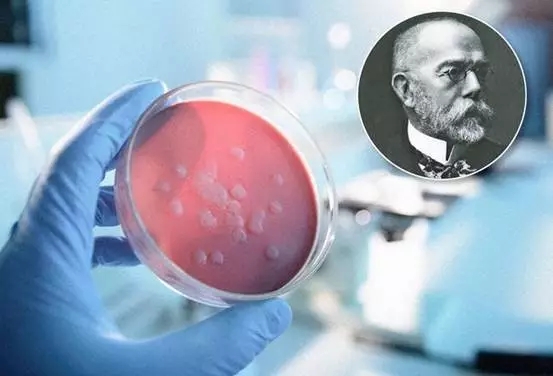
��д5.webp.jpg

医学史上,一些重大的突破性发现往往是通过一条意想不到的迂回曲折路径来呈现于世人面前,这种偏离常规科研方式总是让人惊叹连连。近日,美国著名医学网站Medscape则总结了12个医学史上意外突破性发现,它们的问世得益于科研者敏锐的观察能力,并在极大程度上改变了医学的进程。

1676年,Antony van Leeuwenhoek意外发现了原生动物与细菌,奠定了细菌学和原生动物学基础。他曾寄信给伦敦皇家协会:这些微生物比肉眼可见的水蚤或水虱还要小。
Van Leeuwenhoek作为荷兰黄金时代的一个织物交易商,他最初自制显微镜也只是为了观察布料的质量。然而为了满足丰盛的好奇心,他也通过显微镜观察寻常可见的物质,包括污浊的雨水、“猪舌头”、跳蚤、粪便和精液。而这个贸易繁盛的时代,他早期实验的部分动机也只是希望发现胡椒麻辣的原因。
Van Leeuwenhoek在检查牙齿的牙菌斑时,似乎就已经非常了解细菌在疾病和热巴氏杀菌过程中的作用,并将细菌描述为圆球菌、杆状菌和螺旋菌。

科学界第一个被挖掘出具有麻醉效果的气体是由Humphry Davy发现的NO(一氧化氮),俗名笑气,为手术中麻醉打下了基础。这种气体通过呼吸道进行扩散,最初也只是产生局部的愉悦感,很快就会扩散全身并使其处于麻醉状态。
据了解,Davy是一位极具创造性的谦虚的研究员,曾作为学徒与外科医生-药剂师一起学习。他在出色的智力表现和自我宣传精神下,成为了英国皇家学会的主席,并在19世界早期成为了著名科学家之一。
在其研究生涯中,他分离出了包括NO在内的一些气体。后来作为布里斯托尔气压学会(the Pneumatic Society of Bristol)的实验主管,他希望这些能为消费者提供治疗。他进行了详尽而细致的“自我实验”,这为他赢得了科学机构、追随者、知名人士的尊重。而基于NO能缓解他牙龈疼痛,Davy预测NO将成为手术中麻醉剂,而该预言却在50年后得以实现。同样Davy也是电化学领域的先驱,他不仅发现了镁、钙、锶和钡元素,还为矿工发明了戴维灯(Davy lamp)。

1796年Edward Jenner开创疫苗接种时代,建立了疫苗接种的理论和实践,并于1980年消灭了天花。
18世界末,英国民间乡村普遍认为得过牛痘的人不会再患致死性疾病天花(死亡率高达40%)。除了开展一些其他的著名科学研究,如心绞痛和心脏病发作、古生物学和地质学等,Edward Jenner还敏锐地察觉了牛痘与天花之间的联系,并对乡村里的这个观点保持密切的关注。
他并不是第一个意识到两种疾病之间关系的科学家。在中国明朝、印度和非洲都曾对天花进行预防性接种,而奥斯曼帝国(Ottoman Empire)甚至还进行人痘接种。然而凭着科学的艰苦研究以及严谨性,Jenner被誉为创造了首个疫苗并成为免疫学的奠基人。
为了获得天花疫苗,他在从一个挤奶女工手上收集了牛痘液体后,通过浅表切口将其接种到一个8岁男孩的手臂上。6周后,他给男孩接种了天花病毒,然而男孩并没有产生病理反应,对天花病毒有了一定的免疫能力。
1881年Robert Koch开创了细菌的选择性培养法,首次建立了细菌学科并鉴定出了很多致病病原菌。
Koch发现在实验室意外留下的马铃薯长出了不同颜色的细菌菌落,至此激发了他的灵感,并研发出了一种具有选择性培养细菌的革命性方法,即从海藻中提取物来制备固体培养机制来进行细菌的分离、鉴定和研究。在此之前,细菌均是在液体肉汤中进行培养,根本不可能对细菌进行细分。
Louis Koch与同时代的Louis Pasteur一同为19世纪科学影响力最大的人物之一,其研究工作极大推动了疾病相关病原体的理论建立,并鉴定了多种引起疾病(如炭疽、伤寒、脑膜炎、麻风、破伤风、梅毒和结核病)的病原体。另外,他在1905年获得诺贝尔奖。

1895年,Wilhelm Roentgen发现了“X-ray”,在诊断和治疗方面树立了新的模式,同时创造了新的研究学科并在物理医学领域产生了深刻变革。
在这个发现过程中,物理学家Roentgen在一个真空管中对阴极射线进行实验时,注意到了一个神秘的绿色光芒。Rentent随后注意到“X-ray”的穿透性质,这是一种以前未知的辐射类型。这张著名照片就显示了他妻子的手骨。
X-ray被发现对许多学科均产生了广泛影响,因而Roentgen获得了1901年诺贝尔物理学奖。这也是历史上首次在不进行手术的情况下观察身体的内部情况。但很快,人们就发现了暴露于“X-ray”的危害。

1928年Alexander Fleming发现了青霉素(Penicillin),为细菌感染提供了有效的治疗,并迎来了抗生素的时代。
而对青霉素的抗菌性能的发现却像极了一个不可思议的小说情节,汇集了一连串偶然事件。经过两周的假期后,Fleming意外发现在室温条件下,在长满金黄色葡萄球菌的培养皿中,只有青霉菌周围的葡萄球菌菌落被溶解。在随后的实验中,Fleming指出,这类霉菌所分泌的物质不仅控制了细菌的生长,而且杀死了细菌。
1929年,Flenming在发表的论文提到青霉素可能是一种抗菌素,仅此而已。随后Ernst Chain和Howard Florey的研究挖掘出了青霉素的全部潜力。因而,这三科学家因青霉素的发现以及其在各种感染性疾病的疗效而在1945年共享了诺贝尔生理医学奖。此后,青霉素进入了大规模药物生产的年代。

1889年Oskar Minkowski和Joseph von Mering首次发现了胰腺与糖尿病之间的关系,为胰岛素的发现和糖尿病的治疗铺平了道路。
此次发现则取决于两位科学家思维的偶然碰撞,就像1889年他们在Starsbourg大学图书馆的路径上偶然相遇一般。正因为这个偶然的见面,通过探讨胰腺酶的作用并最终确定了胰腺在糖尿病所起的作用。
为了验证Von Mering的假说,Minkowski手术切除了一只狗的胰腺,并记录了狗的口渴状态和其丰富的含糖(葡萄糖负载)尿液。随后他们发现,移除胰腺的狗所产生的高血糖症状可以通过皮下植入胰腺进行缓解,从而确定了胰腺在维持葡萄糖稳态中的作用。

1940年,Karl Paul Link和Mark Arnold Stahmann所发现的华法林(Warfarin),为广泛使用口服抗凝血剂预防血栓形成奠定了基础。
华法林的发现也是一连串偶然事件产生的必然结果。1933年Wisconsin大学实验站的农业化学家Karl Paul Link以及生物化学研究者Mark Arnold Stahmann均在寻求奶牛大出血死亡的原因。
经过7年的研究,Link发现喂养奶牛的饲料中含有一种单体香豆素会在牧草腐败过程形成双香豆素,可影响维生素K的凝血性能,进而可导致奶牛大出血。随后Link与实验室里的Stahmann合作并合成了若干种香豆素,并申请了相关专利。
此后的若干年内,华法林一直被作为老鼠药使用,直到一名失意的美国海军士兵企图用华法林老鼠药来自杀失败后,人们才发现该药物应用于人体身上意外地还挺安全的。加之临床上确有不少病人需要抗凝血物质华法林,来预防血栓形成来预防血栓形成,华法林才被用作为抗凝药物。从此,抗凝药物的历史翻开了崭新的篇章。

1949年创造了人工晶状体的Harold Ridley提供一种预防失明的先进技术。他作为二战期间的眼外科医生曾检查过皇家空军飞行员Gordon Cleaver的眼睛(被塑料碎片所损坏)。在之后的随访检查中,Rdley注意到飞行员的眼睛并没有对存在的塑料碎片产生负面反应。
基于此次观察以及后续的多年研究,1949年,Ridley决定通过植入塑料透镜来治疗白内障。而该手术在当时被认为是一个具有高度争议性和冒险性的操作,但是手术的成功大大提高了白内障手术治疗效果。如今,人工晶状体植入术在世界范围内已被操作了数百万次,并最终改变了眼睛的护理和眼科的实践过程。

1959年,化学家Leo Sternbach在重新调查二战前夕于Krakow大学从染料中分离出的三环化合物后,发现了苯二氮卓类药物(Benzodiazepines),其中包括diazepam(安定)药物,具有抗焦虑和放松人心情的效果。
上世纪50年代,Sternbach和他的团队研究了数十种化合物,均被证实不具有生物活性。但戏剧性的是,一个原本就要被踢出实验室的化合物,凭着意外的镇静安神效果而在最后一刻从将被毁灭的命运中拯救回来。药物利眠宁(Librium)以及苯二氮卓类药物就此问世。1963年,Diazepam被合成了。在1969年到1982年期间,它就已经是美国最常用的处方药,每年销售峰值可高达与6亿美元。
目前约有30种用于治疗焦虑、肌肉松弛、睡眠障碍、麻醉和癫痫的苯二氮卓类药物在世界各地范围内被使用。而这项杰出的研究也获得了241项专利,此后Sternbach被美国News&World Report评为20世纪中最有影响力的美国人。

1963年,放射科医师Charles Dotter作为20世纪医药领域的牛人,因开创了经皮腔内血管成形术,被人认为是介入放射学之父。同样这个发现也是进行诊断导管研究时所得到意外发现:当他将导管穿过阻塞动脉时,将解决了动脉阻塞的症状。
经皮腔内血管成形术可能是Dotter最重要的医学贡献,但他也创造了其他医学介入技术,包括带气囊导管,双腔球囊导管、安全导丝、经皮动脉支架的概念以及支架移植等。在建立介入放射学科的过程中,Dotter为Andreas Gruentzig的冠状动脉成形术和介入心血管技术的发展铺平了道路。

1982年Barry Marshall和Robin Warren确定了幽门螺杆菌(Helicobacter pylori)在胃炎和消化性胃溃疡中的作用,彻底转变了胃炎和胃溃疡的诊断和治疗。然而,由于这一真相在当时颠覆了传统医学观念:胃炎和胃溃疡是一种自然衰老的过程,没有办法治疗,只能尽量预防和缓解,所以该事实并不被广大学者所接受。
为了证明自己的理论,Marshall和Warren收集了病人的胃粘膜标本进行细菌培养,起初一个成功的都没有,然而在复活节假期回来后竟发现细菌培养板上长出了一个菌斑,并成功证明了幽门螺杆菌是胃溃疡的罪魁祸首,且可用抗生素对其进行治疗。这个发现也帮助他们获得了2005年获诺贝尔生理医学奖。
邮政编码:200052 电话:021-63800152 传真:021-63800151 京ICP备15010734号-10 技术:网至普网站建设